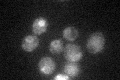
YCR044C

View description
Protein of the endoplasmic reticulum, required for GPI-phospholipase A2 activity that remodels the GPI anchor as a prerequisite for association of GPI-anchored proteins with lipid rafts; functionally complemented by human ortholog PERLD1
Localization:
Intensity:
Fold change:
Significance:
-
C’ GFP library in SD

ER30.94 -
N' NOP1pr-GFP in SD

N/A0 -
N' TEF2pr-mCherry in SD

N/A0 -
N' NATIVEpr-GFP in SD

N/A0 -
N' TEF2pr-VC and Cyto-VN in SD

N/A0 -
C’ GFP library in SD+DTT

ER26.710.86No -
C’ GFP library in SD+H2O2

ER25.910.83No -
C’ GFP library in Starvation Media
ER32.031.03No -
C’ GFP library on the background of Pup2-DaMP

N/A -
C’ GFP library on the background of CCT mutant

N/A0N/AYes
